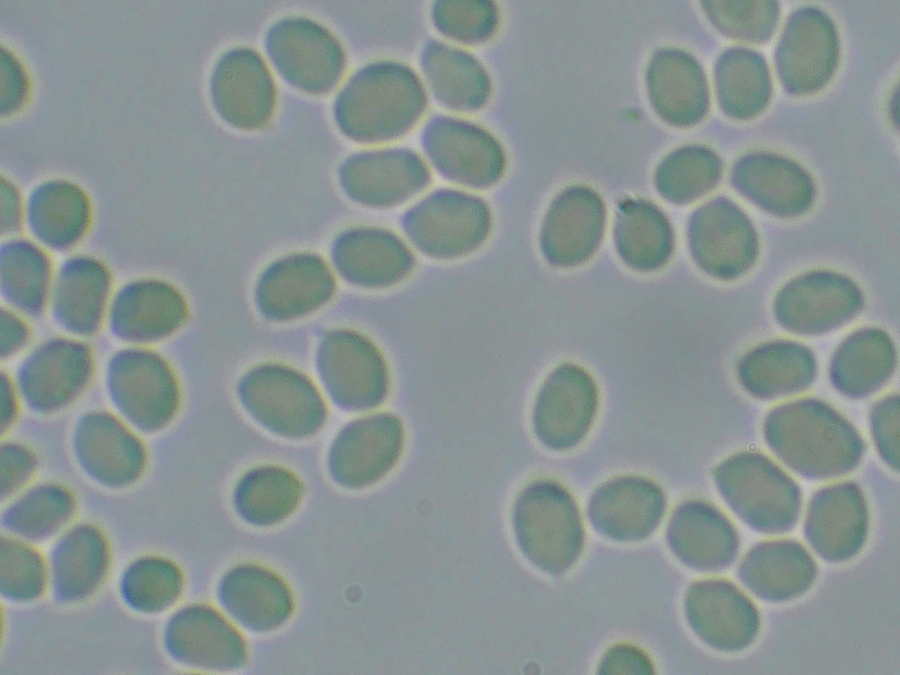

ヒラフスベ-アイカワタケLaetiporus versisporus (Lloyd) Imazeki
■ツガサルノコシカケ科 アイカワタケ属
肉眼的特徴(2025.02.15記述)
発生時期と発生地;
に各種の広葉樹の立ち木-枯れ木に発生する(材の褐色腐朽をおこす)
子実体;
全体が10.0cm-20.0cm余の塊り 個々の傘幅5.0cm-15.0cm×厚さ10-20mm 鮮黄色-汚白色→しだいに汚褐色 半球状の瘤様→瘤の数を増やす→瘤それぞれが成長→しばしば平たい半円形-不整形の棚状の傘 なめらか
傘 ;
径5.0-20.0cm 厚さ1.0-8.0cm 半円形-扇形 重生-単生 縁部波打つ 朱橙色→朱紅色→退色 周辺の成長部は淡色 小凹凸と色合いによる不鮮明な環紋あり
管 孔 ;
なめらか ときに浅い管孔が形成される
肉 ;
白色→中心部から暗褐色→粉のかたまりになる やや締まり弾力がある→硬く脆く砕けやすい→粉のかたまりになる
胞子紋;
以前はヒラフスベと称されてきた本種とアイカワタケは別種扱いだったが、現在はアイカワタケと同種とされている。

■2024年07月06日 撮影地 阿武隈山地

■2024年07月06日 撮影地 阿武隈山地

■2024年07月06日 撮影地 阿武隈山地

■2024年07月06日 撮影地 阿武隈山地

■2024年07月06日 撮影地 阿武隈山地

■2024年07月06日 撮影地 阿武隈山地

■2024年07月06日 撮影地 阿武隈山地
■2024年07月06日 撮影地 阿武隈山地

■2024年07月06日 撮影地 阿武隈山地
■2024年07月02日 撮影地 牡丹園
■科別小画像一覧へ □五十音別図鑑へ